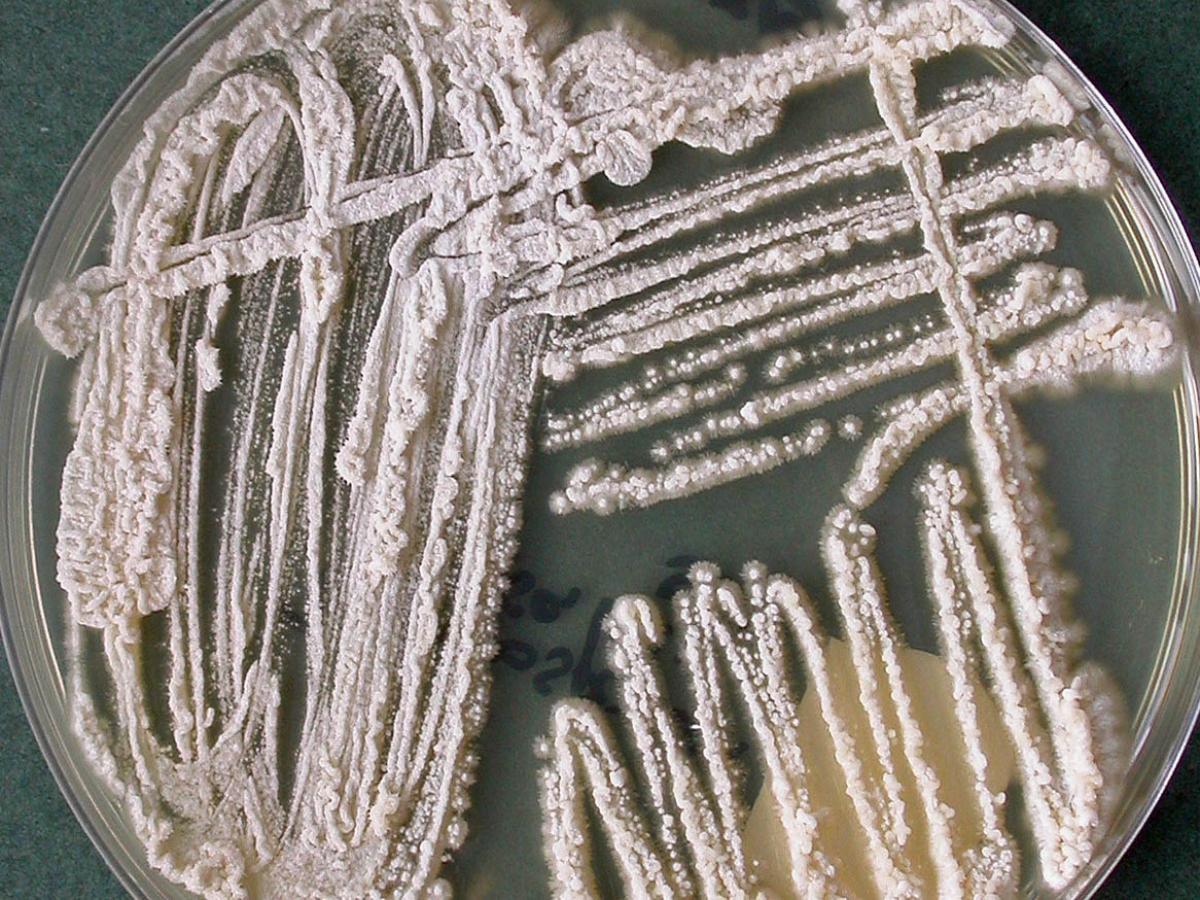
Culture

Unknown 36
Mould identification: a virtual self assessment
Case history
A 43-year-old man with newly diagnosed acute myeloblastic leukaemia and non-insulin-dependent diabetes mellitus developed fungaemia. The diagnosis was based on repeated isolation of the fungus shown below.
Culture

Microscopy
Sugar assimilation results
| Glucose |
+
|
L-Rhamnose |
+
|
| Galactose |
+
|
D-Glucosamine |
+
|
| L-Sorbose |
v
|
N-A-D-glucosamine |
+
|
| Sucrose |
v
|
Glycerol |
v
|
| Maltose |
+
|
Erythritol |
+
|
| Cellobiose |
+
|
Ribitol |
v
|
| Trehalose |
+
|
Galactitol |
-
|
| Lactose |
+
|
D-Mannitol |
v
|
| Melibiose |
-
|
D-Glucitol |
v
|
| Raffinose |
-
|
∝-M-D-glucoside |
+
|
| Melezitose |
v
|
D-Gluconate |
+
|
| Soluble Starch |
v
|
DL-Lactate |
v
|
| D-Xylose |
v
|
myo-Inositol |
v
|
| L-Arabinose |
+
|
Nitrate |
-
|
| D-Arabinose |
+
|
2-K-D-gluconate |
+
|
| D-Ribose |
+
|
D-Glucuronate |
+
|
This species assimilates L-arabinose but not melibiose. Growth at 37C.